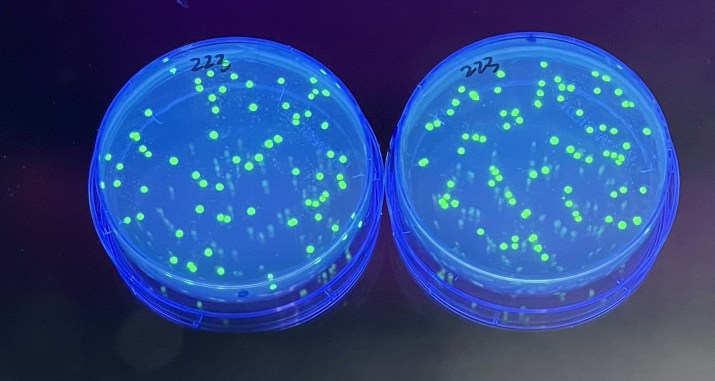

A key component of the HOSA biotechnology event is development of technical skills that take your students out of the books and into the laboratory. That is why we are happy to provide experiments and technical skills tutorials to aid in your training for both components of this competitive event.
Laboratory Basics:

- EdvoTech Tips: Sterilization without an autoclave
- Biotech Basics: Conquering your solutions and dilutions
- Edvotek Instructional Video: Diluting a Concentrated Solution
- Data Analysis: range, mean, median, and mode
- Data Analysis: Collecting and analyzing experimental results
- Data Analysis: What’s in a p-value?
- EdvoTech Tips: How to Read Product Labels and Safety Data Sheets
- Resources: Teach chemical safety using Safety Data Sheets
- Article: A crash course in Lab Safety
- Article: Cleaning up chemical spills in the laboratory
- Biotech Basics: Safety Goggles
Micropipetting:
Pipettes are essential laboratory tools used by scientists to measure and manipulate liquids. They range from simple eye dropper-like devices with squeezable bulbs to advanced robotic systems capable of precise volume dispensing. Micropipettes, in particular, play a crucial role in accurately measuring small volumes, ensuring successful and reproducible experiments.
In biotechnology labs, where reactions involve microliter volumes, scientists rely on piston displacement micropipettes. The accuracy of pipetting is of utmost importance in these experiments, as even minor inconsistencies like air bubbles or extra droplets can disrupt reaction proportions. Therefore, to optimize your students’ laboratory results, it is critical to make sure that they have mastered the technical skill of micropipetting.

- Experiment: Pipetting by Numbers
- Experiment: DNA Duragels to Practice agarose gel loading
- Biotech Basics: Pipetting 101
- How To: Improve your Pipetting Technique
- Biotech Basics: Accuracy and Precision in Measurements
- Edvotek Instructional Video: Pipetting
- Edvotek Instructional Video: How to Calibrate your Pipette
- Edvotek Instructional Video: Measuring liquids with Micropipettes
- Webinar: Micropipetting Basics
Restriction Enzymes:
One of the most significant discoveries in molecular biology belongs to a group of enzymes called restriction endonucleases, also referred to as restriction enzymes. These remarkable enzymes function like molecular scissors by precisely cleaving through the sugar-phosphate DNA backbone based on the specific sequence of nucleotides. The immense utility of restriction enzymes revolutionized numerous scientific endeavors, including molecular cloning, DNA mapping, sequencing, and a wide array of genome-wide studies. This discovery launched the era of modern molecular biotechnology.
- Experiment: Restriction Enzyme Mapping
- Experiment: Cleavage of Lambda DNA with Eco RI Restriction Enzymes
- Experiment: DNA Fingerprinting Using Restriction Enzymes
- Biotech Basics: Restriction Enzymes
- Article: What’s in a name? Restriction enzyme edition
- Quick Guide: Restriction Enzymes
- How to: Drawing a plasmid map
- Edvotek Instructional Video: All About Restriction Enzymes
- Webinar: Construction and Cloning of a DNA Recombinant
- Webinar: Restriction Digests using Kit #225
Agarose Gel Electrophoresis and Gel Interpretation:
Agarose gel electrophoresis is a biotechnology technique that uses electricity and a porous gel matrix to separate mixtures of molecules based on their charge, shape, and size. It is commonly used to separate dyes, proteins, and nucleic acids like DNA and RNA. In particular, it is especially useful in analyzing mixtures of DNA fragments generated by restriction enzyme digestion. During agarose gel electrophoresis, these DNA fragments are separated into distinct bands according to their respective sizes.
- Experiment: Cancer Gene Detection
- Experiment: Cholesterol Diagnostics
- Experiment: DNA Fingerprinting by PCR Amplification
- Biotech Basics: Agarose Gel Electrophoresis
- Biotech Basics: What if I make the wrong percentage agarose gel?
- Biotech Basics: Nine things you didn’t know about electrophoresis
- Agarose Gel Electrophoresis: FAQ Roundup
- Edvotek Instructional Video: Preparing an Agarose Gel for Electrophoresis
- Edvotek Instructional Video: Performing Agarose Gel Electrophoresis
- Edvotek Instructional Video: What is a DNA Ladder and How Do You Use It?
- Edvotek Instructional Video: How does a standard curve work?
Bacterial Transformation and Transformation Efficiency:
In nature, non-essential genes are found on small circular pieces of double-stranded DNA known as plasmids. These plasmids facilitate the exchange of beneficial genes among bacteria and can replicate independently from the cell’s chromosomal DNA. In the lab, we can modify plasmids by introducing genes from various sources. When these engineered plasmids are introduced into bacteria, they transform the bacteria into living factories capable of producing valuable substances like medications, vitamins, and insulin, which is used to treat diabetes.
Since E. coli are not naturally competent, we need to force them to take up plasmid DNA in the lab. This can be done with electricity, in a process called electroporation, or through physical means in a heat shock. In a heat shock transformation, the cells are treated with calcium chloride to make them “competent”. DNA is added to the cells before they are moved quickly between two very different temperatures. It is believed that the combination of calcium chloride and the rapid change in temperature changes the permeability of the cell wall and membrane, allowing DNA molecules to enter the cell.
In practice, transformation is highly inefficient—only one in every 10,000 cells successfully incorporates the plasmid DNA. However, since many cells are used in a transformation experiment (about a billion cells), only a few cells must be transformed to achieve a positive outcome. We can use the data from our experiment to determine how well our transformation worked.
- Experiment: Transformation of E. coli with Green Fluorescent Protein (GFP)
- Experiment: Rainbow Transformation
- Experiment: Exploring Biotechnology with GFP
- Biotech Basics: Bacterial Transformation
- Frequently Asked Questions: Transformation
- Biotech Basics: What is transformation efficiency and why is it important?
- Edvotek Informational Video: Calculating Transformation Efficiency
- Edvotek Informational Video: Preparation of Bacterial Source Plates
- Edvotek Informational Video: Enhanced Transformation Protocol
Qualitative ELISA:
The Enzyme-Linked Immunosorbent Assay, or ELISA, is a highly sensitive test that uses antibodies to detect the presence of specific molecules within a complex sample. is an invaluable tool for researchers, as it can identify even trace amounts of antigens in biological samples, making it ideal for pathogen and allergen detection, among other applications. The fundamental principle of ELISA revolves around the use of antibodies to identify antigens present in the samples. With the capability to generate antibodies for a wide range of molecules, ELISA has emerged as a versatile laboratory test.
- Experiment: Introduction to ELISA Reactions
- Experiment: Experiment: Investigating Human Health Using the ELISA
- Experiment: Vax to the Future: Developing a Vaccine for a Novel Pathogen
- Biotech Basics: All about the ELISA
- Biotech Basics: Mastering the ELISA
- Edvotek Learning Center: The ELISA
- Edvotek Instructional Video: The Enzyme Linked Immunosorbent Assay
- Webinar: Investigating Human Health using the ELISA
- Webinar: Teaching the ELISA using Public Health (HIV Biology and Detection)
Polymerase Chain Reaction (PCR):
In the early 1980’s, Kary Mullis developed a technique that replicated DNA in vitro using short, synthetic DNA oligonucleotides designed to target a specific sequence (known as primers) and DNA Polymerase I. In a process similar to replication in a cell’s nucleus, the primers would bind to the DNA, directing polymerase to copy the gene sequence. However, after the initial elongation, the sample was heated to denature the newly-formed DNA duplex, then cooled to allow primer binding and extension to happen again. Each time the sample cycled through the different temperatures, the amount of DNA doubled. By repeating this cycle of heating and cooling many times, billions of copies of a specific DNA sequence were produced in a matter of minutes. This simple cycle – anneal, extend, denature – is the basis of the polymerase chain reaction. Because of its ease of use and its ability to rapidly amplify DNA, PCR has become indispensable in the medical and life sciences lab.
- Experiment: PCR Amplification of DNA
- Experiment: DNA Fingerprinting Using PCR
- Experiment: SNP Analysis of the PTC Gene Using PCR
- Edvotek Learning Center: Polymerase Chain Reaction (PCR)
- What’s in a name? Exploring different types of PCR
- Biotech Tips: Perfect PCR (Six Tips to PCR Like a Pro)
- Edvotek Informational Video: Ingredients for PCR Success
- Biotech Equipment Tips: Thermal Cyclers
- Webinar: Biotechnology Basics of Human PCR
For more information, visit us at https://www.edvotek.com/hosa